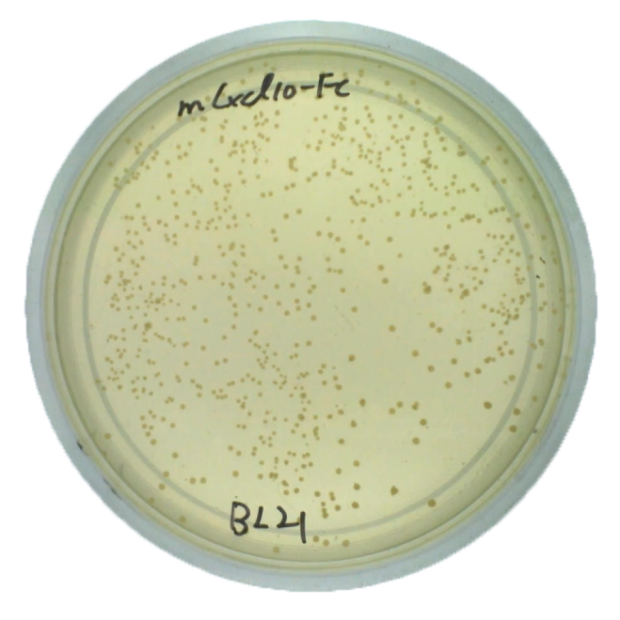

Login Process
1 2 3

- Enter your account and password

- After logging in, select the date at the top of the interface.
- Click the selected date to enter the photo gallery.

- You can download all files at once or select them individually.
- Click on a JPG file to preview it.